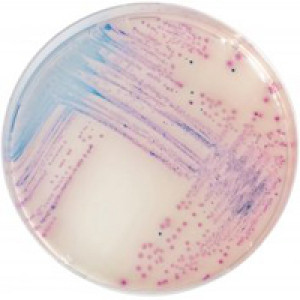

Performance
Infections caused by Salmonella spp, including Salmonella Typhi, remain a major worldwide health problem:
• In the US, Salmonella has an incidence rate of 16.47 cases per 100,000 (CDC estimation, 2010).
• In Europe, it is reported as the first bacterial cause of food outbreaks (EFSA/ECDC 2011 report, 2009 figures)
• In developing countries, Salmonella Typhi and Paratyphi are commonly encountered with an estimated annual incidence of about 17 million cases. (2007 EFSA report)
Moreover, according to a recent WHO report, Salmonella infections are responsible for 2 million deaths per year from diarrhoea. Salmonella is the second most reported zoonotic infection in humans (EFSA/ECDC 2011 report, 2009 figures).
Mainly due to contamination in the food chain and/or during food-production processes, Salmonella commonly induces enteric illness whose major symptoms are abdominal cramps, diarrhea, nausea, vomiting. More severe cases, for instance typhoid cases or infections
Intended Use
CHROMagar™ Salmonella is a selective chromogenic culture medium intended for use in the qualitative direct detection, differentiation, and presumptive identification of Salmonella. The test is performed with rectal swabs and stools, to aid in the diagnosis of Salmonella infections. Results can be interpreted after 18-24 h of aerobic incubation at 35-37 °C.
Concomitant cultures are necessary to recover organisms for further microbiological testing or epidemiological typing. A lack of growth or the absence of mauve colonies on CHROMagar™ Salmonella does not preclude the presence of Salmonella.